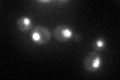
YLR419W
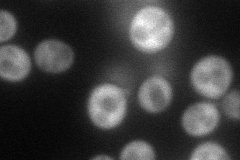
YLR419W
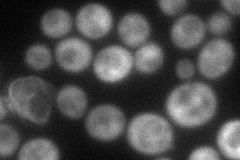
YLR419W
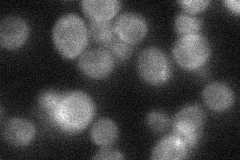
YLR419W

View description
Putative helicase with limited sequence similarity to human Rb protein; the authentic, non-tagged protein is detected in highly purified mitochondria in high-throughput studies; YLR419W is not an essential gene
Localization:
Intensity:
Fold change:
Significance:
-
C’ GFP library in SD
nucleus70.63 -
N' NOP1pr-GFP in SD
cytosol78.3398 -
N' TEF2pr-mCherry in SD
cytosol61.5002 -
N' NATIVEpr-GFP in SD
cytosol30.9888 -
N' TEF2pr-VC and Cyto-VN in SD

#N/A0 -
C’ GFP library in SD+DTT

nucleus56.20.79No -
C’ GFP library in SD+H2O2

nucleus73.841.04No -
C’ GFP library in Starvation Media

nucleus34.550.48Yes -
C’ GFP library on the background of Pup2-DaMP

nucleus -
C’ GFP library on the background of CCT mutant

nucleus80.75581.14323No
